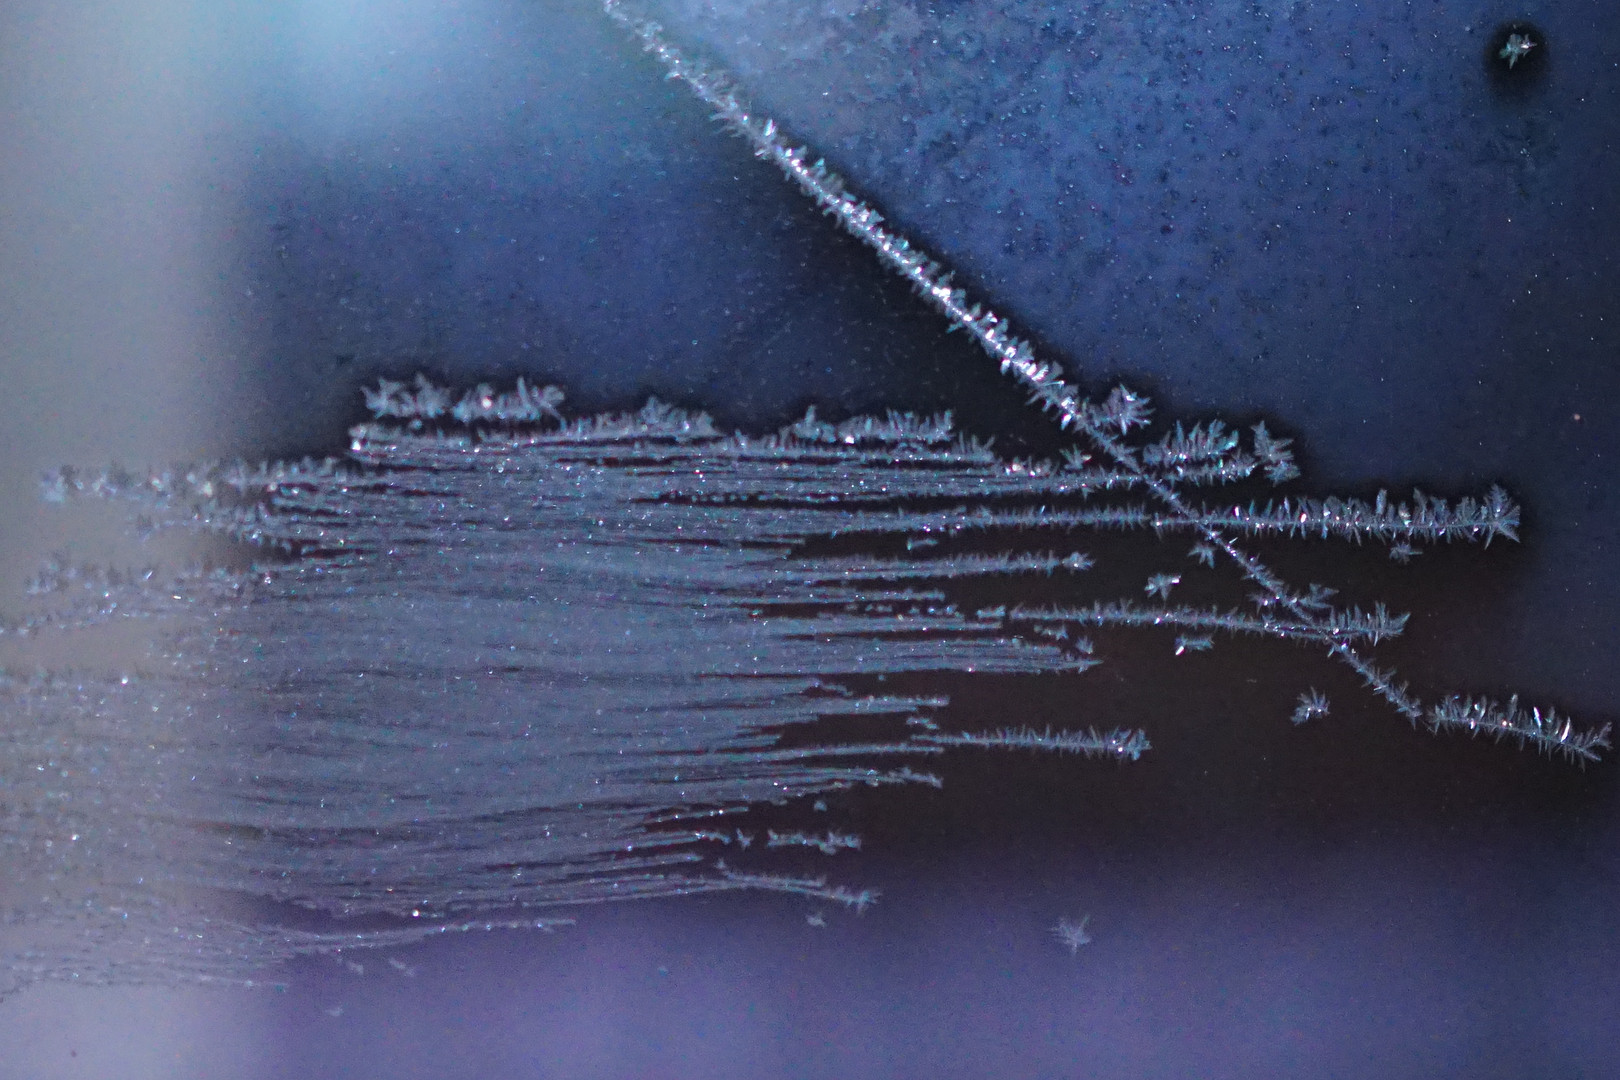

26,262
26,262
2014年7月・・・初投稿、いつのまにかαcafeに参加して丸2年がたっていました。
これを期に初心者マークを外しますね。色んな事に挑戦する割には
長続きしなかった私が続けてこれたのは皆さんのお蔭です。
深夜にこっそり置き豆したり、半分寝ながら投稿したり。。。
皆さんから頂いたコメントにもすぐ、お返しが出来なかったり、申し訳ありません。
カメラを通じて、様々な視点や色々な情報やコメント等、皆さんとふれあうのが楽しいです。最近は中々時間が取れず、ギャラリーに遊びに行く時間がとれず、残念です。もっと、時間が欲しいと思う今日この頃。(2016・8・24)
初めまして!
そして、ご訪問ありがとうございます。2011年にNEX-3を購入してから、
おまかせオートで何も考えず、バシャバシャと撮っておりました。
マクロレンズを今年購入したのをきっかに、カメラの勉強がしたくてαカフェに参加
させて頂いております。
皆さんの作品を見るたびに「驚き、憧れ、溜息」の連続で、時の立つのも忘れます。
お休みの日位しか、ゆっくり鑑賞できなくて残念です。
まだ参加して日も浅く勝手も理解していないので、不手際があればお許し下さい。





/fit-in/148x112/life_contents2/acafe/model_image_cur/model/ILCE-7M2.jpg)

/fit-in/148x112/life_contents2/acafe/model_image_cur/lens/SEL55F18Z.jpg)

コメントを送信する
コメントを送信する
/life_contents2/acafe/others_image_cur/2054/20542848/1/GI02019237363bbf632a3131a.jpg)
/life_contents2/acafe/others_image_cur/2054/20542848/1/GI02019165307dc85ffb08fba.jpg)
/life_contents2/acafe/others_image_cur/2054/20542848/1/GI0201913a93071f98bb793a8.jpg)
/life_contents2/acafe/others_image_cur/2054/20542848/1/GI0201911818e683ca06715c1.jpg)
/life_contents2/acafe/others_image_cur/2054/20542848/1/GI02018f4dbb86e3a7adef83a.jpg)
/life_contents2/acafe/others_image_cur/2054/20542848/1/GI02018eec32a3a107b58a257.jpg)

bravo!数
bravo! さらに
bravo!